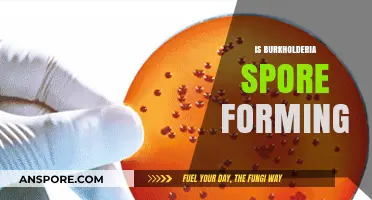
Is Burkholderia Spore-Forming? Unraveling the Bacterial Mystery

Black mold, scientifically known as *Stachybotrys chartarum*, is a type of fungus that thrives in damp, humid environments and can release spores into the air. If you suspect black mold spores are present throughout your house, it’s important to understand that while mold spores are naturally occurring in the environment, their widespread presence indoors is not normal. Mold growth typically indicates underlying issues such as water damage, poor ventilation, or persistent moisture. While small amounts of mold spores are common and usually harmless, high concentrations can pose health risks, especially for individuals with allergies, asthma, or compromised immune systems. Identifying the source of moisture and addressing it promptly is crucial to prevent further mold growth and ensure a healthy living environment.
| Characteristics | Values |
|---|---|
| Natural Occurrence | Black mold spores are naturally present in the environment, both indoors and outdoors. They can enter homes through open doors, windows, vents, and HVAC systems. |
| Growth Conditions | Black mold thrives in damp, humid, and warm environments (typically 77°F to 86°F or 25°C to 30°C). It requires moisture to grow, often found in areas with water damage, leaks, or high humidity. |
| Common Locations | Bathrooms, kitchens, basements, attics, and areas with poor ventilation are prone to black mold growth. It can also grow on organic materials like wood, drywall, carpet, and fabric. |
| Health Risks | Exposure to black mold spores can cause allergic reactions, respiratory issues, headaches, skin irritation, and in severe cases, toxic effects from mycotoxins produced by certain species (e.g., Stachybotrys chartarum). |
| Prevention | Reduce indoor humidity below 60%, fix leaks promptly, ensure proper ventilation, and clean areas prone to moisture regularly. |
| Remediation | Small areas (<10 sq. ft. or 1 sq. meter) can be cleaned with detergent and water. Larger infestations require professional mold remediation to prevent spore spread. |
| Testing | Air quality tests or mold test kits can detect spore levels, but professional inspection is recommended for accurate identification and assessment. |
| Natural Removal | Natural remedies like vinegar, baking soda, or hydrogen peroxide can help clean surface mold, but they do not eliminate the root cause of moisture. |
| Spores in Air | Black mold spores are microscopic and can remain airborne, making them difficult to eliminate completely. Regular cleaning and humidity control are essential. |
| Long-Term Solutions | Install dehumidifiers, use mold-resistant products, and improve insulation to prevent recurring mold growth. |
What You'll Learn

Sources of black mold spores indoors
Black mold spores are a common concern for homeowners, but understanding their sources is the first step in managing their presence. These spores are naturally occurring and can enter your home through various means, often without you even noticing. One of the primary sources is outdoor air. When you open windows or doors, especially in humid or damp conditions, mold spores can easily float inside. These spores are lightweight and can travel long distances, making it nearly impossible to keep them entirely out of your living space.
Another significant source of black mold spores indoors is household plants. While plants add aesthetic value and improve air quality, their soil can harbor mold spores. Overwatering plants or allowing water to accumulate in saucers beneath pots creates a damp environment ideal for mold growth. As the mold matures, it releases spores into the air, which can then spread throughout your home. To mitigate this, ensure proper drainage for your plants and avoid overwatering. Consider using a moisture meter to monitor soil conditions, especially for indoor plants in humid environments.
Leaky pipes and poor ventilation are also culprits in the spread of black mold spores. Moisture from plumbing leaks, whether visible or hidden, provides the perfect breeding ground for mold. Bathrooms, kitchens, and basements are particularly vulnerable due to their high moisture levels. Regularly inspect these areas for signs of leaks, such as water stains or musty odors. Installing exhaust fans in bathrooms and kitchens can significantly reduce humidity, making these spaces less hospitable to mold. Additionally, fixing leaks promptly and ensuring proper insulation can prevent mold from taking hold.
Everyday activities can inadvertently introduce black mold spores into your home. Bringing in items from outdoors, such as shoes, clothing, or firewood, can carry spores inside. Even your pets can track in mold spores on their fur after being outside. To minimize this, establish a routine of removing shoes at the door and wiping down pets’ paws after walks. Vacuuming regularly with a HEPA filter can also help capture spores before they settle and grow. By being mindful of these everyday sources, you can reduce the likelihood of mold spores becoming a persistent issue.
Finally, building materials and furniture can sometimes be sources of black mold spores. Materials like drywall, wood, and fabric can retain moisture, especially if they’ve been exposed to water damage or high humidity. Furniture placed against exterior walls or in damp basements is particularly at risk. If you suspect mold growth in these materials, it’s crucial to address the issue promptly. In some cases, professional remediation may be necessary to remove contaminated materials and prevent further spread. Investing in dehumidifiers and maintaining optimal indoor humidity levels (between 30-50%) can also protect your home from mold-friendly conditions.
Mastering the Art of Creating Perfect Cubensis Spore Prints
You may want to see also

Health risks associated with black mold exposure
Black mold, scientifically known as Stachybotrys chartarum, thrives in damp, humid environments and can release spores that spread throughout your home. While no house is entirely free of mold spores, their concentration and the presence of toxic black mold can pose significant health risks. Understanding these risks is crucial for anyone suspecting mold infestation.
The respiratory system bears the brunt of black mold exposure. Inhaling spores can trigger allergic reactions, including sneezing, runny nose, and itchy eyes, particularly in sensitive individuals. Prolonged exposure may lead to more severe conditions like asthma attacks or the development of asthma in previously healthy individuals. A 2004 Institute of Medicine (IOM) report highlights a strong link between indoor mold exposure and respiratory symptoms, especially in children. For instance, a study published in the *Journal of Allergy and Clinical Immunology* found that infants living in mold-infested homes had a significantly higher risk of developing asthma by age 7.
Skin and eye irritation are common, yet often overlooked, symptoms. Direct contact with mold or its spores can cause redness, itching, and even dermatitis. Eye irritation, such as redness and blurred vision, may occur when spores come into contact with the eyes. These symptoms are typically mild but can be persistent and uncomfortable. For example, a person handling moldy materials without protective gear might experience a rash or skin inflammation within hours of exposure.
Toxic effects from black mold are a serious concern, especially for vulnerable populations. Mycotoxins produced by Stachybotrys chartarum can lead to more severe health issues when inhaled or ingested. While rare, cases of pulmonary hemorrhage in infants have been associated with high levels of black mold exposure. The CDC emphasizes that such severe reactions are not common but underscores the importance of addressing mold problems promptly. For adults, prolonged exposure to mycotoxins may result in chronic fatigue, headaches, and even cognitive issues, though research in this area is still evolving.
Prevention and mitigation are key to minimizing health risks. Regularly inspect your home for signs of mold, particularly in areas prone to moisture, such as basements, bathrooms, and kitchens. Use dehumidifiers to maintain indoor humidity below 60%, and promptly fix any leaks or water damage. If mold is detected, small areas (less than 10 square feet) can often be cleaned with a solution of bleach and water. However, for larger infestations or if you suspect black mold, consult professionals to ensure safe and effective removal. Wearing protective gear, such as gloves and masks, during cleanup is essential to avoid direct exposure.
Children, the elderly, and immunocompromised individuals require special consideration. These groups are more susceptible to the adverse effects of mold exposure. For instance, children’s developing respiratory systems make them more vulnerable to asthma and other respiratory conditions. The EPA recommends that households with young children or elderly members take proactive measures to prevent mold growth and address any issues immediately. Simple steps like ensuring proper ventilation, using exhaust fans in bathrooms and kitchens, and regularly cleaning areas prone to dampness can significantly reduce the risk of mold-related health problems.
Can 25 Micron Filters Effectively Capture and Remove Mildew Spores?
You may want to see also

Preventing black mold growth naturally
Black mold spores are ubiquitous, floating through the air and settling on surfaces both indoors and outdoors. While their presence is natural, their proliferation into visible colonies is not—and it’s entirely preventable. The key lies in disrupting the conditions that allow mold to thrive: moisture, warmth, and organic material. By targeting these factors, you can halt mold growth without resorting to harsh chemicals.
One of the most effective natural methods to prevent black mold is controlling humidity levels. Mold spores germinate in environments with humidity above 60%, so invest in a hygrometer to monitor your home’s moisture content. Aim to keep humidity below 50% using dehumidifiers, especially in damp areas like basements, bathrooms, and kitchens. Pair this with proper ventilation—open windows, use exhaust fans, and ensure air circulates freely. For a DIY solution, place desiccant packets or bowls of uncooked rice in enclosed spaces to absorb excess moisture.
Another natural approach involves leveraging mold-inhibiting substances. Tea tree oil, for instance, is a potent antifungal agent. Mix 1 teaspoon of tea tree oil with 1 cup of water in a spray bottle, shake well, and apply to mold-prone surfaces like shower tiles or window sills. Grapefruit seed extract is another option; dilute 20 drops in 2 cups of water and use it similarly. Both solutions are safe for most surfaces but test a small area first to avoid discoloration. Regular application can create an environment hostile to mold growth.
Prevention also extends to your home’s structural integrity. Inspect for leaks in pipes, roofs, and walls, as even minor water intrusion can foster mold. Repair cracks in foundations and seal windows to prevent condensation. Opt for mold-resistant materials when renovating, such as moisture-resistant drywall or paint infused with antimicrobial agents. For existing surfaces, clean with a mixture of baking soda and vinegar—1 cup of baking soda to 1 cup of white vinegar—to neutralize mold-friendly pH levels and remove organic residue.
Finally, consider the role of sunlight and airflow. Mold thrives in dark, stagnant environments, so maximize natural light by keeping curtains open and trimming outdoor foliage that blocks windows. Rearrange furniture to avoid blocking vents and promote air circulation. In colder months, insulate pipes to prevent condensation and run fans intermittently to disrupt still air. These simple, natural strategies collectively create an environment where black mold struggles to take hold, ensuring your home remains healthy and mold-free.
Mastering Spore's Universe: Creative Ways to Utilize Spit Effectively
You may want to see also

Identifying black mold in your home
Black mold, scientifically known as Stachybotrys chartarum, thrives in damp, humid environments, making it a common household concern. Identifying its presence early is crucial, as prolonged exposure can lead to health issues such as respiratory problems, allergies, and even more severe conditions in vulnerable individuals. While mold spores are naturally present in the air, their concentration and visibility in your home are not. Recognizing the signs of black mold requires a keen eye and an understanding of its preferred habitats.
Visual Inspection: The First Line of Defense
Black mold often appears as dark green or black patches with a slimy or fuzzy texture, though it can also look dry and powdery. Common hiding spots include areas with moisture issues, such as basements, bathrooms, and kitchens. Look for discoloration on walls, ceilings, or floors, especially behind furniture, under sinks, or around windows. A musty, earthy odor is another telltale sign, though not all molds produce a noticeable smell. If you spot suspicious growth, avoid touching it, as disturbing mold can release spores into the air, exacerbating the problem.
Testing for Confirmation
While visual inspection is a good starting point, definitive identification often requires testing. DIY mold test kits are available, but their accuracy can vary. For reliable results, consider hiring a professional mold inspector. They use tools like moisture meters and air quality tests to assess the extent of the problem. If black mold is confirmed, remediation should be handled by experts to ensure safe and thorough removal, especially in cases of widespread infestation.
Preventive Measures to Limit Growth
Identifying black mold is only half the battle; preventing its recurrence is equally important. Maintain indoor humidity below 60% using dehumidifiers or air conditioners. Fix leaks promptly, ensure proper ventilation in moisture-prone areas, and clean surfaces regularly with mold-inhibiting solutions. For example, a mixture of one cup of bleach per gallon of water can be effective for non-porous surfaces, but always test a small area first to avoid damage. Regularly inspect vulnerable areas, particularly after water damage or flooding, to catch mold early.
Health Considerations and When to Act
If you or your family members experience symptoms like persistent coughing, sneezing, or skin irritation, and you suspect mold, act immediately. Children, the elderly, and individuals with compromised immune systems are particularly at risk. Even if mold is not visible, persistent symptoms warrant professional inspection. Early intervention not only protects your health but also prevents costly structural damage to your home. Remember, while mold spores are natural, their unchecked growth indoors is not—and it’s a problem you can control with vigilance and proactive measures.
Mastering Spore Prints: A Step-by-Step Guide for Cubensis Mushrooms
You may want to see also

Natural remedies to remove black mold
Black mold spores are a common concern for homeowners, but not all mold growth requires harsh chemicals to eradicate. Natural remedies can be effective, especially for small to moderate infestations, and they offer a safer, eco-friendly alternative. One of the most accessible and affordable solutions is vinegar, a mild acid that kills 82% of mold species. To use, simply spray undiluted white vinegar onto the affected area, let it sit for an hour, then scrub with a brush and wipe clean. Repeat as needed for stubborn spots. Vinegar’s strong smell dissipates quickly, leaving no harmful residue.
For those seeking a more potent natural remedy, tea tree oil is a powerful antifungal agent. Mix one teaspoon of tea tree oil with one cup of water in a spray bottle, shake well, and apply directly to moldy surfaces. Allow it to dry without rinsing, as the oil’s residual properties help prevent regrowth. While tea tree oil is highly effective, it’s more expensive than vinegar and should be used sparingly due to its concentrated nature. Always test a small area first, as it may discolor certain surfaces.
Another household staple, baking soda, not only absorbs moisture but also inhibits mold growth. Create a paste by mixing one tablespoon of baking soda with a few drops of water, apply it to the moldy area, and let it dry. Scrub off the residue with a damp cloth. For larger areas, combine baking soda with vinegar for a fizzy, mold-busting solution. This combination is particularly effective in bathrooms and kitchens, where mold thrives in damp environments.
While natural remedies are effective, prevention is key. Mold requires moisture to grow, so address the root cause by fixing leaks, improving ventilation, and maintaining humidity levels below 60%. Regularly clean areas prone to dampness, such as shower tiles and basement walls, to prevent spores from taking hold. Natural remedies are not only kinder to your home and health but also empower you to tackle mold proactively and sustainably.
Can Mold Spores Cause a Burning Sensation in Your Throat?
You may want to see also
Frequently asked questions
Black mold spores are naturally present in the environment, both indoors and outdoors. However, finding them "all over" your house suggests excessive growth, which is not normal and indicates a moisture problem or poor ventilation.
Yes, black mold spores can travel through the air and settle in various areas of your home, even if visible mold is not present. However, widespread spores typically indicate hidden mold growth or high humidity levels.
While low levels of mold spores are common, high concentrations can pose health risks, especially for individuals with allergies, asthma, or weakened immune systems. Addressing the source of mold growth is essential for a safe living environment.